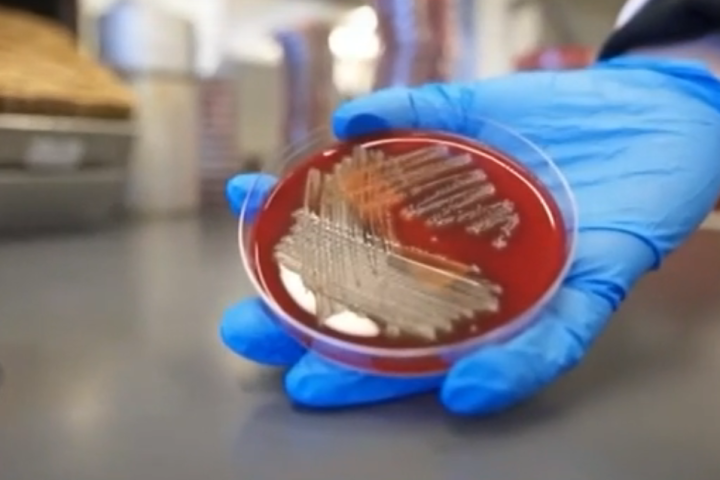

Η ακράτεια δεν είναι μόνιμη: Πώς οι ειδικοί αποκαθιστούν τη λειτουργία μετά από καρκίνο προστάτη
Η ακράτεια ούρων μετά από χειρουργείο προστάτη είναι ένα από τα συχνότερα — και πιο φοβιστικά — συμπτώματα που μπορεί να αντιμετωπίσει ένας άνδρας.